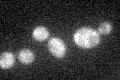

View description
Component of the nonsense-mediated mRNA decay (NMD) pathway, along with Nam7p and Nmd2p; involved in decay of mRNA containing nonsense codons; involved in telomere maintenance
Localization:
Intensity:
Fold change:
Significance:
-
C’ GFP library in SD

cytosol31.84 -
N' NOP1pr-GFP in SD

cytosol,punctate68.4814 -
N' TEF2pr-mCherry in SD

punctate73.295 -
N' NATIVEpr-GFP in SD

cytosol34.642 -
N' TEF2pr-VC and Cyto-VN in SD

punctate41.2234 -
C’ GFP library in SD+DTT

cytosol23.770.74No -
C’ GFP library in SD+H2O2
cytosol26.540.83No -
C’ GFP library in Starvation Media

cytosol34.781.09No -
C’ GFP library on the background of Pup2-DaMP

cytosol -
C’ GFP library on the background of CCT mutant

cytosol27.08490.850404No
